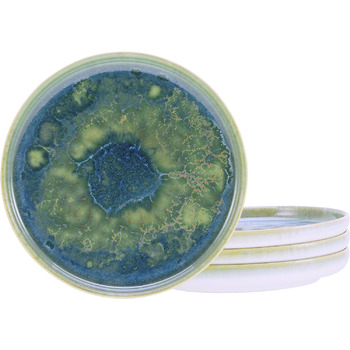
Серія Юкі, (хлібна тарілка 4 шт.), 21509

Десертна тарілка 22 см, набір 4 предмети, Yuki Creatable
1)Наявність кредитної картки Приват банку
2)Доступний ліміт по сервісу "Оплата частинами", який перевищує вартість покупки
3)Наявність на карті коштів на перший платіж. Перший платіж +Х-1 наступних Детальніше
1)Наявність кредитної картки Приват банку
2)Доступний ліміт по сервісу "Миттєва розстрочка", який перевищує вартість покупки
3)Наявність на карті коштів на перший платіж. Перший платіж +Х-1 наступних Детальніше
1. Бути клієнтом monobank 2. Мати смартфон з додатком monobank
3. Перевірити доступний ліміт на покупку частинами
4. Мати доступний баланс на рахунку кредитної карти для списання першого платежу.) Детальніше
Десертна тарілка 22 см, набір 4 предмети, Yuki Creatable
- Реактивна глазур, кожен виріб унікальний.
- Спеціальна нагорода German Design Award 2023
- Зроблено в Португалії
Незвичайний дизайн виробів серії Yuki нещодавно був нагороджений German Design Award 2023.
У наборі 4 тарілки.
Діаметр тарілки: 22 см.
Колір: різнокольоровий.
Матеріал: керамограніт.
Зроблено у Португалії компанією MESA.